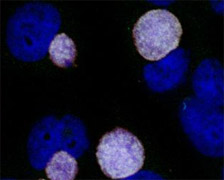

This viva contains pathology questions for final MRCOphth candidates.
|
The above specimen was taken from another infant with ophthalmia neonatorum.What test has been performed on the specimen ?
What can be seen in the slide?
Next questions
| ............................ |
This viva contains pathology questions for final MRCOphth candidates.
The above specimen was taken from another infant with ophthalmia neonatorum. |